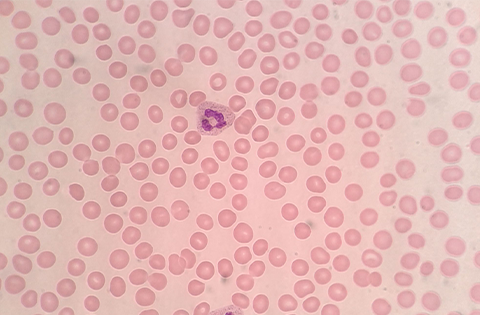
Púrpura trombocitopénica inmune (PTI)

Patologías No Oncológicas
Tratamiento especializado para trastornos hematológicos benignos: anemias, problemas de coagulación, alteraciones plaquetarias y más.
Trastornos Hematológicos Benignos
Estos trastornos pueden deberse a múltiples causas: hereditarias, deficiencias de vitaminas o minerales, o reacciones del sistema inmune.

Anemia
Disminución de glóbulos rojos o hemoglobina en la sangre
Trastorno de glóbulos rojos
Anemia por deficiencia de hierro
Anemia causada por falta de hierro en el organismo
Trastorno de glóbulos rojos
Anemia por deficiencia vitamínica
Anemia causada por falta de vitaminas como B12 o ácido fólico
Trastorno de glóbulos rojos
Anemia aplásica
Fallo de la médula ósea para producir células sanguíneas
Trastorno de glóbulos rojos
Anemia Hemolítica Autoinmune
Destrucción de glóbulos rojos por el sistema inmunitario
Trastorno de glóbulos rojos
Trombocitopenia (plaquetas bajas)
Disminución del número de plaquetas en la sangre
Trastorno de plaquetas
Trombocitosis
Aumento del número de plaquetas en la sangre
Trastorno de plaquetas
Púrpura trombocitopénica inmune (PTI)
Destrucción de plaquetas por anticuerpos autoinmunes
Trastorno de plaquetas
Trastornos hemorrágicos
Alteraciones que causan sangrado excesivo
Trastorno de coagulación
Trombosis venosa profunda
Formación de coágulos en venas profundas
Trastorno de coagulación
Trastornos de leucocitos
Alteraciones en el número o función de glóbulos blancos
Trastorno de glóbulos blancos
Síndrome hipereosinofílico
Aumento persistente de eosinófilos en sangre
Trastorno de glóbulos blancosDiagnóstico Preciso y Tratamiento Efectivo
Muchos trastornos hematológicos no oncológicos tienen tratamientos muy efectivos. Nuestro equipo puede ayudarle a obtener un diagnóstico preciso y un plan de tratamiento personalizado.
